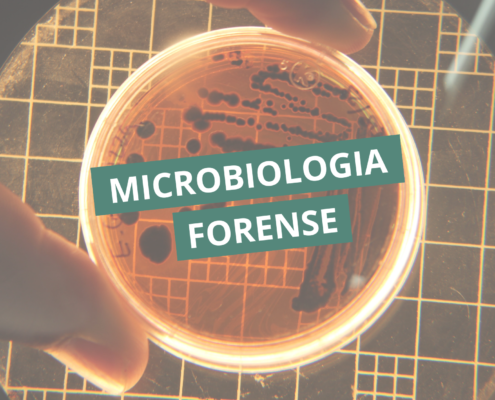

Posts

Descubra Seu Estilo de Aprendizado e Transforme Sua Carreira.
Você já parou para pensar como você aprende melhor? Cada pessoa tem uma maneira única de absorver e reter informações, e identificar o seu estilo de aprendizado pode ser o segredo para potencializar seus estudos e alcançar novos patamares…

A Encruzilhada na Carreira de Dois Profissionais de Análises Clínicas: Uma História de Escolhas e Oportunidades
No coração de um renomado laboratório de análises clínicas, dois profissionais compartilhavam não apenas o ambiente de trabalho, mas também uma jornada que começou na mesma época, dez anos atrás. Guilherme, um biomédico entusiasmado,…

Procrastinando a pós-graduação? Veja o quanto isso está custando por mês
Existe um tipo de atraso que não aparece no extrato bancário, não gera cobrança imediata e, por isso, costuma ser ignorado: o atraso da própria evolução profissional.
Adiar a pós-graduação parece apenas uma decisão de tempo. Mas,…

Você é bom no que faz, mas o RH nem te chama. Por quê?
No cenário da área da saúde, é comum encontrar profissionais tecnicamente competentes, com bom domínio teórico e até experiência prática, mas que ainda assim enfrentam dificuldades para avançar em processos seletivos ou conquistar…

Transfusão maciça
A transfusão maciça é uma intervenção crítica em medicina transfusional e cuidados de emergência, utilizada em situações de hemorragia grave com risco iminente de morte. Trata-se da reposição rápida e controlada de grandes volumes…

Por que profissionais de saúde experientes estão perdendo vagas para recém-formados especializados
O mercado da saúde sempre valorizou a experiência prática como um dos principais pilares de um bom profissional. Durante anos, construir uma carreira sólida na área da saúde significava, principalmente, acumular tempo de atuação e desenvolver…

Patógenos Respiratórios
As infecções do trato respiratório representam uma das principais causas de morbidade em todo o mundo, abrangendo desde quadros leves até condições graves com potencial de complicações sistêmicas. Nesse contexto, a compreensão dos…

Gerenciamento do Sangue do Paciente (PBM)
O gerenciamento do sangue do paciente, conhecido internacionalmente como Patient Blood Management (PBM), é uma abordagem baseada em evidências que tem transformado a prática transfusional moderna. Seu foco central é otimizar o cuidado ao…
Microbiologia forense
A interface entre ciência e justiça tem se expandido de forma significativa nas últimas décadas, impulsionada pelo avanço das técnicas laboratoriais e pela crescente complexidade das investigações criminais. Nesse cenário, a microbiologia…

Urocultura
A urocultura é um dos exames microbiológicos mais solicitados na prática clínica, sendo fundamental para o diagnóstico de infecções do trato urinário. Por meio da identificação e quantificação de microrganismos presentes na urina,…

Evidências Ocultas
Em investigações criminais, nem todos os vestígios estão visíveis a olho nu. Muitos elementos essenciais à elucidação de um crime são evidências ocultas, que exigem técnicas específicas de identificação e análise. A compreensão…

Marcadores de inflamação
A inflamação é uma resposta biológica complexa a estímulos nocivos, como patógenos, tecidos danificados ou agentes químicos. Nos laboratórios clínicos, a avaliação de marcadores de inflamação é essencial para o diagnóstico, monitoramento…
